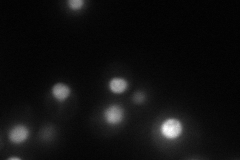
YNR053C
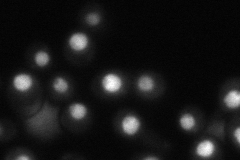
YNR053C

View description
Putative GTPase that associates with pre-60S ribosomal subunits in the nucleolus and is required for their nuclear export and maturation
Localization:
Intensity:
Fold change:
Significance:
-
C’ GFP library in SD

nucleus110.51 -
N' NOP1pr-GFP in SD
nucleus63.4702 -
N' TEF2pr-mCherry in SD

missing0 -
N' NATIVEpr-GFP in SD
nucleus52.2905 -
N' TEF2pr-VC and Cyto-VN in SD

nucleus30.668 -
C’ GFP library in SD+DTT

nucleus73.940.66No -
C’ GFP library in SD+H2O2

nucleus130.891.18No -
C’ GFP library in Starvation Media

nucleus25.80.23Yes -
C’ GFP library on the background of Pup2-DaMP

N/A -
C’ GFP library on the background of CCT mutant

N/A0N/AYes
